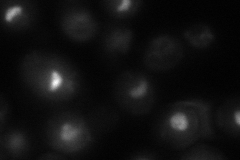
YLR175W

View description
Pseudouridine synthase catalytic subunit of box H/ACA small nucleolar ribonucleoprotein particles (snoRNPs), acts on both large and small rRNAs and on snRNA U2; mutations in human ortholog dyskerin cause the disorder dyskeratosis congenita
Localization:
Intensity:
Fold change:
Significance:
-
C’ GFP library in SD

below threshold16.3 -
N' NOP1pr-GFP in SD

nucleolus323.786 -
N' TEF2pr-mCherry in SD

nucleolus107.683 -
N' NATIVEpr-GFP in SD

nucleolus155.682 -
N' TEF2pr-VC and Cyto-VN in SD
nucleolus52.1826 -
C’ GFP library in SD+DTT

cytosol18.191.11No -
C’ GFP library in SD+H2O2

cytosol16.120.98No -
C’ GFP library in Starvation Media

cytosol13.240.81No -
C’ GFP library on the background of Pup2-DaMP

below threshold -
C’ GFP library on the background of CCT mutant

below threshold17.67671.0841No
